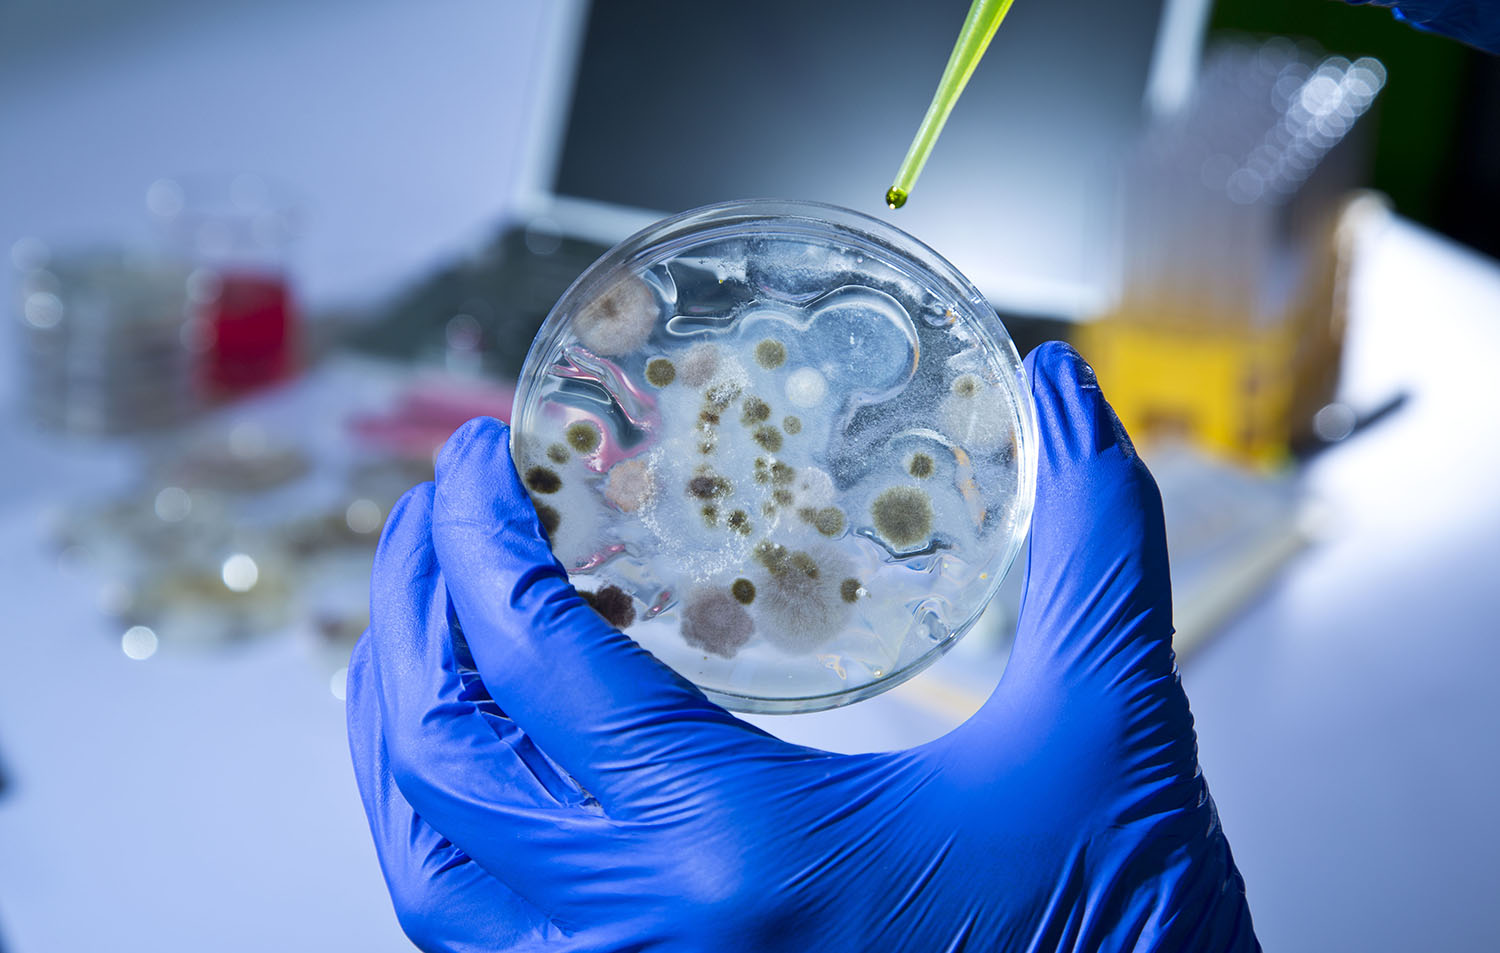
Analytical Dairy Testing

-
 We Cover All SectorsAnimal Health Products
We Cover All SectorsAnimal Health Products -
 We Cover All SectorsFood Safety Testing
We Cover All SectorsFood Safety Testing -
We Cover All SectorsAnalytical Dairy Testing
We Cover All SectorsAnalytical Dairy Testing -
 We Cover All SectorsTest Laboratories
We Cover All SectorsTest Laboratories -
 We Cover All SectorsNutritional Laboratories
We Cover All SectorsNutritional Laboratories -
 We Cover All SectorsChemical Analytical Testing
We Cover All SectorsChemical Analytical Testing -
 We Cover All SectorsResearch & Development
We Cover All SectorsResearch & Development -
 We Cover All SectorsDiagnostic Testing
We Cover All SectorsDiagnostic Testing